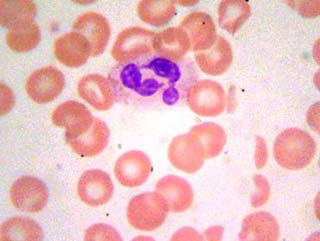
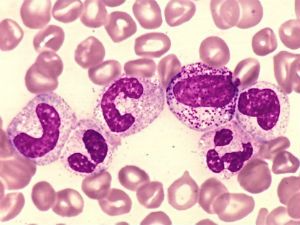

Нейтрофилы — ключевые элементы иммунной системы, защищающие организм от инфекций и воспалений. Повышенный уровень нейтрофилов в крови может указывать на бактериальные и вирусные инфекции, воспалительные реакции или стресс. В этой статье рассмотрим, что означает повышенное содержание нейтрофилов, причины этого явления и дальнейшие шаги для диагностики и лечения. Понимание этих аспектов поможет читателям лучше ориентироваться в анализах и своевременно реагировать на изменения в здоровье.
Какие бывают виды нейтрофилов и зачем нужны
Эти белые кровяные клетки формируются в костном мозге. Их основная функция заключается в поддержании нормального функционирования иммунной системы. Каждую минуту в организме вырабатывается примерно 7 миллионов лейкоцитов. Эти клетки крови способны распознавать и поглощать патогенные бактерии, а также продукты распада тканей.
Таким образом, у взрослого человека всегда имеется запас этих жизненно важных клеток.
Существует шесть типов нейтрофилов, которые различаются в зависимости от стадии их развития:
- миелобласты;
- промиелоциты;
- миелоциты;
- метамиелоциты;
- палочкоядерные;
- сегментоядерные.
Повышенный уровень нейтрофилов в анализе крови может свидетельствовать о наличии воспалительного процесса в организме. Врачи отмечают, что такие изменения часто наблюдаются при инфекциях, как бактериальных, так и вирусных. Нейтрофилы — это тип белых кровяных клеток, которые играют ключевую роль в иммунной защите, и их увеличение может указывать на активную борьбу организма с патогенами.
Однако важно учитывать, что повышение нейтрофилов может быть связано не только с инфекциями, но и с другими состояниями, такими как стресс, травмы или хронические заболевания. Врачи рекомендуют проводить дополнительные исследования для определения причины изменения уровня нейтрофилов и назначения соответствующего лечения. Правильная интерпретация результатов анализа крови требует комплексного подхода и учета клинической картины пациента.

Нормы содержания
Их количество у человека варьируется от 45 до 70 процентов от общего числа всех лейкоцитов. В одном кубическом дециметре крови как у мужчин, так и у женщин содержится от 1,8 до 6,5 миллиардов клеток.
В норме доля палочкоядерных нейтрофилов должна составлять от 1 до 5 процентов. Сегментоядерные (зрелые) нейтрофилы должны составлять не менее 40 и не более 68 процентов от общего числа этих клеток. Остальные виды лейкоцитов занимают оставшуюся часть объема.
| Показатель | Значение | Возможное значение |
|---|---|---|
| Нейтрофилы | Повышены (нейтрофилия) | Острая бактериальная инфекция (пневмония, аппендицит, менингит, сепсис) |
| Воспалительные процессы (ревматоидный артрит, панкреатит, воспалительные заболевания кишечника) | ||
| Травмы, ожоги, хирургические вмешательства | ||
| Стресс, физическое перенапряжение | ||
| Прием некоторых лекарств (кортикостероиды, адреналин) | ||
| Злокачественные новообразования (особенно миелопролиферативные заболевания) | ||
| Курение | ||
| Беременность (физиологическая нейтрофилия) | ||
| Отравления (свинец, ртуть) | ||
| Острые кровотечения |
Повышенные показатели в крови
Высокие абсолютные значения уровня нейтрофилов наблюдаются, когда на определенный объем крови их количество превышает норму.
Относительное увеличение нейтрофилов фиксируется, когда в единице крови наблюдается рост именно этих клеток, в то время как количество других типов лейкоцитов остается на стабильном уровне. Это явление называется сдвигом лейкоцитарной формулы, и его основной причиной является бактериальная инфекция.
Физиологический нейтрофилез может возникать в следующих ситуациях:
- при интенсивных физических нагрузках;
- после приема пищи;
- в период беременности;
- после сильных психоэмоциональных стрессов.
Во время беременности нейтрофилез может считаться нормальным, так как развивающийся плод воспринимается организмом как чуждое тело. В результате в организме женщины увеличивается количество всех типов лейкоцитов.
Увеличение образования лейкоцитов также может происходить из-за роста токсинов в крови.
Если уровень нейтрофилов значительно превышает норму, это может представлять серьезную угрозу для плода, так как иммунная система матери может начать реагировать на него как на инородное тело. Резкое увеличение нейтрофилов может указывать на риск выкидыша.
Важно отметить, что палочкоядерные нейтрофилы появляются в крови даже при незначительном развитии инфекционного процесса. Однако, если наблюдается значительное увеличение метамиелоцитов и миелоцитов, это свидетельствует о том, что организм борется с инфекцией на пределе своих возможностей. Аналогичная ситуация может возникнуть и при вирусной инфекции.

Почему важно знать показатель
Все типы лейкоцитов присутствуют в организме в различных пропорциях. Когда эти пропорции находятся в норме, это свидетельствует о том, что иммунная система функционирует эффективно и согласованно.
Изменение уровня нейтрофилов по сравнению с другими клетками указывает на так называемый сдвиг лейкоцитарной формулы вправо.
Знание количества нейтрофилов имеет большое значение для раннего выявления воспалительных, инфекционных и других заболеваний. Для более точной диагностики отдельно подсчитываются палочкоядерные и сегментоядерные клетки.
Возможные причины высоких значений нейтрофилов
Если общий анализ крови показывает увеличение уровня нейтрофилов, это может указывать на наличие воспалительного процесса в организме. Особенно заметно повышение этих клеток наблюдается при гнойных заболеваниях.
К основным причинам нейтрофилеза можно отнести:
- гемолитические анемии, возникающие в результате кровопотери;
- бактериальные инфекции, такие как пневмония, тонзиллит, скарлатина, абсцессы, менингиты, гнойные воспаления, воспаление желчного пузыря, маточных труб, плеврит и тромбофлебит;
- воспалительные заболевания, включая ревматизм и ревматоидный артрит;
- нарушения в работе сердечной мышцы;
- дерматит, псориаз и другие кожные заболевания;
- обширные ожоги;
- острая тяжелая почечная недостаточность;
- трофические язвы;
- сепсис;
- гангрена;
- эритремия;
- остеомиелофиброз;
- применение глюкокортикостероидов, адренокортикотропного гормона и других медикаментов;
- опухолевые процессы, связанные с распадом опухолей;
- интоксикация ядами насекомых;
- отравление скипидаром, углекислым газом, гепарином и казеином;
- гипергликемическая кома;
- аллергические реакции;
- глистные инвазии.
Наиболее заметное увеличение нейтрофилов наблюдается при гнойных процессах. В таких случаях говорят о значительном сдвиге лейкоцитарной формулы влево.

Что значит для человека повышенный уровень нейтрофилов
Если количество этих клеток крови достигает 10 миллиардов на литр, это может указывать на развитие воспалительного процесса в определенной области организма.
Если же число этих клеток не превышает 20 миллиардов на литр, это может свидетельствовать о наличии более обширного патологического процесса.
В некоторых случаях этот показатель может увеличиваться до 60 миллиардов на кубический дециметр.
Длительное повышение абсолютного уровня нейтрофилов указывает на генерализованное воспаление. Это состояние может возникать при таких заболеваниях, как холера, сепсис и других серьезных патологиях.
Увеличение числа нейтрофилов также свидетельствует о том, что организм активно борется с инфекцией. Таким образом, нейтрофилез может быть нормальной реакцией иммунной системы на присутствие бактериального агента. Иногда это состояние может быть вызвано приемом определенных медикаментов.
Факт изменения физиологического уровня нейтрофилов говорит о необходимости проведения тщательного диагностического обследования.
Анализы крови
Анализ на уровень этих элементов в крови назначается при подозрении на следующие заболевания:
- пневмония (если у пациента наблюдается сильный кашель);
- ревматические болезни;
- воспаление почек;
- новообразования;
- дерматологические заболевания;
- анемия;
- диабет.
Количество этих клеток может быть представлено как в абсолютных значениях, так и в процентах. Эти данные играют важную роль в процессе диагностики. Процентное соотношение нейтрофилов может варьироваться в зависимости от используемых реактивов.
Для анализа кровь берется из вены натощак. Важно, чтобы исследование проводилось в одинаковых условиях. После забора кровь помещается на стерильное предметное стекло и изучается под микроскопом. Лаборант подсчитывает количество белых кровяных клеток по специальной методике.
Как снизить количество нейтрофилов
На сегодняшний день не существует средств, способных непосредственно снизить уровень нейтрофилов в крови. Врач, как правило, назначает лечение, направленное на устранение основного заболевания. Если увеличение числа этих клеток связано с инфекционными процессами, пациенту могут быть прописаны антибиотики.
Чаще всего используются антибактериальные препараты с широким спектром действия:
- пенициллиновые антибиотики – Ампициллин, Тикарциллин, Амоксициллин;
- антибиотики из группы тетрациклинов;
- фторхинолоны – Левофлоксацин, Ципрофлоксацин, Офлоксацин;
- аминогликозиды;
- амфениколы – Левомицетин и его аналоги;
- карбапенемы – Меропенем, Эртапенем.
Если же повышение уровня нейтрофилов связано с приемом медикаментов, требуется корректировка лечения. При недостатке питательных веществ в организме рекомендуется специальная диета. Также может быть полезен прием витаминных комплексов и микроэлементов. В случае аллергических реакций назначаются антигистаминные препараты.
Возможные осложнения нейтрофилеза
Наиболее серьезное осложнение нейтрофилеза связано с тяжелым течением инфекционного процесса. Если не оказать своевременную медицинскую помощь, развитие сепсиса может привести к летальному исходу.
При увеличении уровня нейтрофилов у женщин в период беременности существует угроза выкидыша или преждевременных родов. В таких ситуациях необходима интенсивная поддерживающая терапия.
Повышенное содержание нейтрофилов в крови у взрослых зачастую указывает на наличие инфекционного процесса в организме. Врачи, как правило, назначают эффективное лечение основного заболевания. Если причина нейтрофилеза будет устранена, уровень лейкоцитов нормализуется в течение нескольких недель.
Общий (клинический) анализ крови включает множество показателей, по которым врач может оценить состояние здоровья пациента. Изменение значений каждого из этих показателей может свидетельствовать о развитии различных патологий в организме. Одним из ключевых показателей развернутого общего анализа крови является количество нейтрофилов. Рассмотрим, что означает этот показатель и какие изменения в количестве нейтрофилов могут указывать на проблемы в организме.
Нейтрофилы в крови человека
Нейтрофилы являются самым многочисленным типом лейкоцитов в крови (белые кровяные клетки, играющие ключевую роль в иммунной системе организма).
Эти клетки формируются в красном костном мозге из гранулоцитарного предшественника. Нейтрофилы относятся к гранулоцитарным клеткам, которые содержат гранулы в своей цитоплазме. В этих гранулах находятся такие вещества, как миелопероксидаза, лизоцим, катионные белки, кислые и нейтральные гидролазы, коллагеназа, лактоферрин и аминопептидаза. Благодаря этому набору веществ нейтрофилы выполняют важные функции в организме, проникая из крови в ткани и органы, где они уничтожают патогенные микроорганизмы. Уничтожение происходит через фагоцитоз, когда нейтрофилы поглощают и переваривают чуждые частицы, в результате чего сами погибают.
Существуют шесть стадий созревания нейтрофилов: миелобласт, промиелоцит, метамиелоцит (юная клетка), палочкоядерная и сегментоядерная. Сегментоядерные нейтрофилы считаются зрелыми клетками, имеющими ядро, разделенное на сегменты. Остальные формы являются незрелыми. В крови человека значительно больше сегментоядерных нейтрофилов по сравнению с незрелыми клетками. При наличии инфекции или воспалительного процесса костный мозг активно выделяет в кровь незрелые формы нейтрофилов. По количеству таких клеток в анализе крови можно определить наличие инфекционного процесса и его активность.
Большая часть нейтрофилов (примерно 60%) находится в костном мозге, чуть менее 40% располагается в органах и тканях, и лишь около 1% нейтрофилов циркулирует в периферической крови. Согласно анализу крови, в норме в периферической крови должны присутствовать только сегментоядерные и палочкоядерные клетки.
После выхода из костного мозга нейтрофилы циркулируют в периферической крови в течение нескольких часов, после чего мигрируют в ткани. Их продолжительность жизни в тканях составляет от 2 до 48 часов, в зависимости от наличия воспалительного процесса. Нейтрофилы определяются в общем анализе крови при подсчете лейкоцитарной формулы, которая показывает процентное содержание различных видов лейкоцитов относительно их общего количества.
Расшифровка анализа крови на нейтрофилы
Норма
Нормальные показатели нейтрофилов в общем анализе крови у взрослых варьируются от 45 до 70% от общего числа лейкоцитов, что соответствует диапазону 1,8-6,5×10^9 /л. У детей содержание нейтрофилов в крови зависит от их возраста. Для малышей до одного года норма составляет 30-50% или 1,8-8,4×10^9 /л, для детей до семи лет – 35-55% или 2,0-6,0×10^9 /л, а для подростков до 12 лет – 40-60% или 2,2-6,5×10^9 /л.
В рамках общего числа нейтрофилов нормальные значения сегментоядерных форм составляют 40-68%, в то время как палочкоядерные формы должны находиться в пределах 1-5%.
Повышенные значения
Увеличение числа нейтрофилов, известное как нейтрофилез, представляет собой специфическую реакцию организма на инфекцию и воспаление. Чаще всего нейтрофилез сопровождается лейкоцитозом, то есть увеличением общего числа лейкоцитов. При этом рост палочкоядерных нейтрофилов может свидетельствовать о наличии бактериальной инфекции.
Небольшое увеличение уровня нейтрофилов в крови может наблюдаться в результате интенсивных физических нагрузок, сильного стресса, после обильного приема пищи или во время беременности.
Однако значительное повышение количества нейтрофилов в анализе крови может указывать на наличие следующих заболеваний:
- умеренный или локализованный воспалительный процесс (уровень нейтрофилов достигает 10,0×10^9/л);
- обширный воспалительный процесс в организме (уровень нейтрофилов может подняться до 20,0×10^9/л);
- генерализованный воспалительный процесс, например, при сепсисе, вызванном стафилококками (уровень нейтрофилов может варьироваться от 40,0 до 60,0×10^9/л);
Состояние, при котором в крови обнаруживаются незрелые формы нейтрофилов (миелоциты, промиелоциты), а также увеличивается количество палочкоядерных и юных форм, называется сдвигом лейкоцитарной формулы влево. Это явление часто наблюдается при тяжелых и обширных инфекциях, особенно при гнойных процессах.
Пониженные значения
Снижение уровня нейтрофилов в крови, известное как нейтропения, свидетельствует о нарушении функций или органическом угнетении кроветворения в костном мозге. Одной из причин нейтропении может быть активное разрушение нейтрофилов под воздействием токсических веществ, антител к лейкоцитам или циркулирующих иммунных комплексов. Обычно понижение уровня нейтрофилов наблюдается при ослаблении иммунной системы организма.
Медицинские специалисты выделяют несколько типов нейтропении: врожденную, приобретенную и нейтропению неясного происхождения. Хроническая доброкачественная нейтропения часто встречается у детей младше одного года. В норме такое состояние может наблюдаться у детей до двух-трех лет, после чего уровень нейтрофилов должен вернуться к норме.
Снижение нейтрофилов в анализе крови чаще всего связано с рядом заболеваний и состояний, включая:
- вирусные инфекции (грипп, краснуха, корь);
- бактериальные инфекции (брюшной тиф, бруцеллез, паратиф);
- протозойные инфекции (токсоплазмоз, малярия);
- риккетсиозные инфекции (сыпной тиф);
- тяжелые воспалительные заболевания, которые могут принимать форму генерализованного инфекционного процесса;
- апластическая и гипопластическая анемии;
- агранулоцитоз (значительное снижение количества нейтрофилов);
- гиперспленизм (уменьшение лейкоцитов, эритроцитов и тромбоцитов из-за их разрушения или накопления в увеличенной селезенке);
- лучевая терапия и радиационное облучение;
- выраженный дефицит массы тела, кахексия (крайнее истощение);
- прием некоторых медикаментов (сульфаниламиды, цитостатики, анальгетики, левомицетин, пенициллины).
В некоторых случаях снижение уровня нейтрофилов может быть временным и кратковременным. Например, такое состояние может наблюдаться во время противовирусной терапии. Эта форма нейтропении обратима и проходит после прекращения приема препаратов. Однако если уровень нейтрофилов остается низким в течение длительного времени, это может указывать на развитие хронического заболевания кроветворной системы. Кроме того, если низкое содержание нейтрофилов сохраняется более трех суток, возрастает риск инфекционных заболеваний.
Нейтрофильные гранулоциты представляют собой важнейшую подгруппу лейкоцитов, отвечающую за уничтожение вредных инородных агентов, таких как бактерии, грибы, вирусы и паразиты, которые могут вызывать серьезные заболевания у человека.
Эти клетки выполняют крайне важные функции, и поэтому даже небольшие изменения в их количестве часто вызывают беспокойство у пациентов, получивших результаты общего анализа крови. Особенно настораживает ситуация, когда уровень нейтрофилов повышен. Что же может означать такое явление?
Как выглядит повышенное содержание гранулоцитов в бланке анализов
Для начала стоит отметить, что существует два основных типа защитных кровяных клеток:
- Палочкоядерные – это молодые формы нейтрофилов, которые имеют характерное вытянутое ядро без перегородок. Они находятся в красном костном мозге до момента созревания, после чего попадают в кровоток, создавая защитный барьер иммунной системы.
- Сегментоядерные – более зрелые нейтрофилы, обладающие полноценными функциями для борьбы с патогенными микроорганизмами (например, высокой подвижностью и способностью поглощать до 30 различных опасных форм жизни до своей гибели). Их ядро имеет необычную структуру, состоящую из нескольких сегментов. Большое количество этих клеток находится в организме, некоторые из них циркулируют в крови, а другие оседают на стенках лимфатических сосудов и внутренних органов, формируя резерв.
В анализах крови графа «нейтрофилы» или «нейтрофильные гранулоциты» делится на две категории, в каждой из которых обычно можно увидеть процентное соотношение двух типов этих клеток. В таблице ниже представлены ориентировочные показатели превышения нормы защитных лейкоцитов в зависимости от возраста пациентов:
| Возрастная группа | Параметры нейтрофилии (%) | |
| Палочкоядерные | Сегментоядерные | |
| Первые 24 часа жизни | >16–17 | >79–80 |
| 2–30 дней | >13–14 | >60 |
| 2–12 месяцев | >5–6 | >45 |
| 2–3 года | >5–6 | >58 |
| 4–6 лет | >5–6 | >60 |
| 7–12 лет | >5–6 | >65 |
| 13–15 лет | >5 | >68 |
| 16+ | >5 | >73–75 |
Важно помнить, что у новорожденных высокие показатели являются нормой в большинстве случаев. В дальнейшем, особенно до 3–4 лет, количество нейтрофилов будет значительно колебаться: сначала оно уменьшится (примерно до 1 года), а затем начнет постепенно увеличиваться.
Период с 5–6 до 14–15 лет характеризуется относительной стабильностью, хотя возможны небольшие колебания из-за активного физиологического роста. У подростков старше 15–16 лет показатели нейтрофилов уже сопоставимы с таковыми у взрослых мужчин и женщин. Уровень гранулоцитарных лейкоцитов в организме не зависит от пола, а определяется состоянием здоровья и возрастом.
Также в результатах клинического анализа крови иногда указывается абсолютное количество нейтрофилов – это значение, умноженное на 10⁹, которое отражает общее количество защитных клеток в одном литре крови. Повышенный уровень лейкоцитов (нейтрофилия) классифицируется следующим образом:
| Количество нейтрофилов (×10⁹) | Степень отклонения |
| 7–10 | Умеренная |
| 11–20 | Выраженная (достаточно острая) |
| >21 | Тяжелая (требующая немедленного медицинского вмешательства) |
Не всегда высокий уровень нейтрофилов представляет угрозу для жизни пациента, однако важно обратиться к врачу для выяснения причин изменений. В некоторых анализах нейтрофилы могут обозначаться международной аббревиатурой – NE или NEUT.
Причины повышения нейтрофилов в крови
Нейтрофилия не является самостоятельным заболеванием, а представляет собой симптом, который может указывать на множество различных заболеваний, способных вызвать такое состояние. Часто повышенное количество гранулоцитов может быть вызвано обычными физиологическими изменениями, такими как, например, интенсивные физические нагрузки. Рассмотрим это более подробно.
Заболевания как провокаторы нейтрофилии
Прежде всего, значительное увеличение уровня нейтрофилов может свидетельствовать о наличии различных воспалительных процессов на ранних или острых стадиях (в скобках указаны соответствующие органы, чтобы избежать путаницы в терминологии):
- Нефрит (почки).
- Тромбофлебит (венозные сосуды).
- Аппендицит (червеобразный отросток слепой кишки).
- Сальпинит (маточные трубы).
- Перитонит (брюшная полость).
- Холангит (желчные протоки).
- Остеомиелит (костные ткани).
- Гнойный плеврит (серозная оболочка легких).
- Ринит (слизистая носа).
- Дерматит (кожа).
- Ревматоидный артрит (суставы).
- Острый холецистит (желчный пузырь).
- Отит (все отделы уха, включая внутреннее ухо).
- Менингит (оболочки головного и спинного мозга).
- Запущенный бронхит (бронхи легких).
- Панкреатит (поджелудочная железа).
- Цистит (мочевой пузырь).
- Тонзиллит (небные и глоточные миндалины).
- Эндокардит (внутренняя оболочка сердца).
- Клещевой энцефалит (головной мозг).
- Флегмона (подкожная жировая клетчатка).
Не менее часто к повышению уровня нейтрофилов могут приводить и другие состояния:
- Псориаз.
- Туберкулез.
- Инфаркт миокарда.
- Почечная недостаточность.
- Пневмония.
- Инсульт.
- Микоз или грибковая инфекция (в основном увеличиваются сегментоядерные гранулоциты).
- Подагра.
- Мочекаменная болезнь.
- Холера.
- Глистная инвазия.
- Различные формы некроза, такие как гангрена.
- Дизентерия.
- Цирроз печени, вызванный чрезмерным употреблением алкоголя.
- Ботулизм.
Онкологические заболевания на поздних стадиях также могут вызывать повышенное выделение нейтрофилов (в то время как в период химиотерапии уровень защитных лейкоцитов, наоборот, значительно снижен). Аналогично обстоит дело и с заболеваниями, связанными с нарушением кроветворения, такими как геморрагическая анемия или эритремия.
Если повышенный уровень нейтрофилов сопровождается резким ухудшением состояния (появление синяков на коже, боли в области желудочно-кишечного тракта и головы, высокая температура, постоянная тошнота, обильное потоотделение и т.д.), человеку следует незамедлительно обратиться к врачу для выяснения причин.
Непатологические основания для развития нейтрофилии
Недостатков, связанных с избытком нейтрофилов, действительно много, однако в большинстве случаев увеличение количества гранулоцитов обусловлено безобидными физиологическими состояниями. Если человек привык регулярно употреблять обильные порции пищи и пробовать новые продукты, то с высокой вероятностью у него будет обнаружено повышение нейтрофилов в крови после общего анализа с лейкоцитарной формулой.
Подозрительные результаты могут возникнуть из-за постоянного переживания психологических стрессов, хронической тревожности, длительной депрессии и эмоционального напряжения. У женщин за несколько дней до начала менструации также часто наблюдается нейтрофилия, которая не указывает на наличие каких-либо заболеваний.
Если общий анализ крови был сдан вскоре после перенесенного острого тяжелого заболевания бактериальной, грибковой или вирусной природы, скорее всего, у пациента будут обнаружены повышенные нейтрофилы. Регулярное использование некоторых медикаментов также может влиять на уровень гранулоцитов. Например, настойка наперстянки, гепарин, эпинефрин и фенацетин способны повышать их количество.
После хирургического вмешательства, особенно при значительной кровопотере, у пациента обязательно будут повышены нейтрофилы, а также лимфоциты и моноциты, которые активно участвуют в очищении организма от мертвых клеток и сгустков крови. В то же время может наблюдаться снижение уровня гемоглобина.
Любовь к спортивным занятиям, танцам и активному образу жизни также может отражаться на анализах крови. Постоянная физическая активность и силовые нагрузки часто приводят к увеличению содержания нейтрофилов.
У маленьких детей с любой формой пищевой аллергии также могут наблюдаться повышенные нейтрофилы, как и у беременных женщин. Родителям, чьи дети собираются сдавать анализ крови с лейкоцитарной формулой, будет полезно ознакомиться с этой статьей, в которой рассматриваются показатели нейтрофилов в крови у детей.
Опасно ли увеличение нейтрофилов у беременной женщины?
Учитывая, что уровень гранулоцитарных ядерных клеток у беременных женщин может, как и у других людей, быть связан с ранее упомянутыми отклонениями, игнорировать нейтрофилию определенно не следует — это может привести к негативным последствиям как для матери, так и для её ребенка.
Тем не менее, небольшое превышение нормы на ранних сроках беременности считается вполне естественным. Это связано с тем, что организм женщины воспринимает развивающуюся жизнь как потенциальную угрозу, в результате чего нейтрофилы начинают активно вырабатываться до момента «принятия» этой новой жизни. В период гестации у женщин может наблюдаться уровень нейтрофилов до 8–10×10⁹.
Такое увеличение является нормальным, хотя для мужчин, детей и небеременных женщин этот показатель считается довольно высоким. Критическое превышение уровня нейтрофилов (более 40–60×10⁹) может сигнализировать о риске выкидыша или преждевременных родов. Поэтому, с целью обеспечения безопасности, специалисты настоятельно рекомендуют будущим матерям регулярно проходить медицинские осмотры.
Существует ли вероятность получения ложного результата?
Да, и эта проблема вовсе не незначительна. В большинстве случаев она возникает из-за того, что пациенты не соблюдают простейшие правила подготовки к общему анализу крови. Люди часто не осознают, что их образ жизни непосредственно влияет на состав крови, что затрудняет врачам получение точной информации о состоянии здоровья.
Наиболее распространённые причины, приводящие к ложным результатам с превышением нормы, включают:
- Приём пищи менее чем за 7–8 часов до анализа.
- Употребление алкоголя незадолго до сдачи образца.
- Утреннее употребление кофе, энергетических напитков или крепкого чая перед процедурой (разрешена только чистая вода).
- Курение за 1–2 часа до посещения лаборатории.
- Интенсивные физические нагрузки в течение 2–3 дней перед анализом.
В редких случаях сотрудники медицинских лабораторий могут перепутать образцы крови, что приводит к некоторым ошибкам в интерпретации результатов для конкретных пациентов. Чтобы избежать подобных недоразумений, врачи часто назначают повторное исследование крови.
Можно ли заниматься самолечением
Поскольку человек без медицинского образования не способен самостоятельно установить точный диагноз, заниматься лечением без консультации специалиста крайне не рекомендуется. До тех пор, пока не будет выявлена истинная причина повышенного уровня нейтрофилов, использование любых народных средств, химических препаратов и гомеопатии строго запрещено.
Кроме того, неправильное сочетание медикаментов может усугубить течение заболевания. Вопросы здоровья следует решать совместно с врачом, желательно, чтобы это был опытный и зарекомендовавший себя специалист.
Методы диагностики и исследования
Для диагностики повышенного уровня нейтрофилов в крови применяются различные методы, позволяющие определить как количественные, так и качественные характеристики этих клеток. Основным методом является общий анализ крови, который позволяет получить информацию о количестве нейтрофилов, их процентном соотношении к другим клеткам крови, а также о наличии других отклонений.
Общий анализ крови включает в себя подсчет различных форменных элементов, среди которых выделяют палочкоядерные и сегментоядерные нейтрофилы. Увеличение их количества может указывать на острые воспалительные процессы, инфекции или другие патологические состояния. Результаты анализа могут быть представлены в виде абсолютного числа нейтрофилов на литр крови или в процентном соотношении к общему количеству лейкоцитов.
Для более детального изучения состояния нейтрофилов могут быть использованы дополнительные методы, такие как:
- Биохимический анализ крови: позволяет оценить функциональное состояние органов и систем, что может помочь в выявлении причин повышения нейтрофилов.
- Иммуноферментный анализ: используется для определения специфических маркеров воспаления и инфекций, что может дать более полное представление о состоянии пациента.
- Микроскопическое исследование мазка крови: позволяет оценить морфологию нейтрофилов и выявить возможные аномалии, такие как наличие токсических гранул или изменения в форме клеток.
Кроме того, в некоторых случаях может потребоваться проведение дополнительных исследований, таких как:
- Культура крови: для выявления бактериальных инфекций.
- ПЦР-диагностика: для определения вирусных инфекций.
- УЗИ органов брюшной полости: для выявления воспалительных процессов в внутренних органах.
Важно отметить, что интерпретация результатов анализа должна проводиться квалифицированным специалистом, так как повышение уровня нейтрофилов может быть связано с различными факторами, включая стресс, физическую нагрузку, аллергические реакции и даже беременность. Поэтому для точной диагностики необходимо учитывать клиническую картину и сопутствующие симптомы.
Рекомендации по дальнейшим действиям при повышенных нейтрофилах
При получении результатов анализа крови, в которых отмечено повышение уровня нейтрофилов, важно не паниковать, а внимательно подойти к дальнейшим действиям. Нейтрофилы — это тип белых кровяных клеток, которые играют ключевую роль в иммунной системе, защищая организм от инфекций и воспалений. Повышение их уровня может свидетельствовать о различных состояниях, и для правильной интерпретации результатов необходимо учитывать множество факторов.
Первым шагом после получения анализа является консультация с врачом. Специалист сможет оценить результаты в контексте других показателей анализа крови, а также учитывать клинические симптомы и историю болезни пациента. Важно сообщить врачу о любых недомоганиях, таких как лихорадка, боли, усталость или другие проявления, которые могут помочь в диагностике.
Если уровень нейтрофилов повышен, врач может назначить дополнительные исследования для выяснения причины. Это могут быть:
- Общий анализ крови с подсчетом лейкоцитов и их формулой;
- Биохимический анализ крови для оценки функции печени и почек;
- Микробиологические исследования для выявления инфекций;
- Иммунологические тесты, если есть подозрение на аутоиммунные заболевания;
- Обследование на наличие опухолей, если есть соответствующие показания.
В зависимости от выявленной причины повышения нейтрофилов, врач может рекомендовать различные подходы к лечению. Если причиной является инфекция, может потребоваться назначение антибиотиков или противовирусных препаратов. В случае воспалительных заболеваний могут быть рекомендованы противовоспалительные средства. Если же повышение нейтрофилов связано с более серьезными состояниями, такими как рак, может потребоваться комплексное лечение, включая химиотерапию или хирургическое вмешательство.
Кроме того, важно обратить внимание на образ жизни и питание. Употребление здоровой пищи, богатой витаминами и минералами, регулярные физические нагрузки и достаточный отдых могут способствовать укреплению иммунной системы и нормализации уровня нейтрофилов. Избегание стрессов и вредных привычек, таких как курение и чрезмерное употребление алкоголя, также может оказать положительное влияние на общее состояние здоровья.
Наконец, регулярные медицинские осмотры и контроль за состоянием здоровья помогут своевременно выявлять изменения в анализах и принимать необходимые меры. Не стоит забывать, что повышение нейтрофилов — это лишь один из показателей, и его интерпретация должна проводиться в комплексе с другими данными и симптомами.
Профилактика повышения уровня нейтрофилов
Профилактика повышения уровня нейтрофилов в крови является важным аспектом поддержания общего здоровья и предотвращения различных заболеваний. Нейтрофилы — это тип белых кровяных клеток, которые играют ключевую роль в иммунной системе, защищая организм от инфекций и воспалений. Однако их уровень может повышаться по различным причинам, включая инфекции, воспалительные процессы, стресс и другие факторы. Поэтому важно знать, как можно предотвратить это состояние.
Одним из основных методов профилактики является поддержание здорового образа жизни. Это включает в себя сбалансированное питание, богатое витаминами и минералами, регулярные физические нагрузки, достаточный сон и управление стрессом. Употребление пищи, богатой антиоксидантами, такими как фрукты и овощи, может помочь укрепить иммунную систему и снизить риск воспалительных процессов.
Также стоит обратить внимание на регулярные медицинские осмотры и анализы крови. Раннее выявление изменений в уровне нейтрофилов может помочь в своевременной диагностике и лечении заболеваний, которые могут привести к их повышению. Если у вас есть хронические заболевания, такие как диабет или заболевания сердца, важно следить за их состоянием и соблюдать рекомендации врача.
Избегание стрессовых ситуаций и умение управлять стрессом также играют важную роль в профилактике повышения уровня нейтрофилов. Хронический стресс может вызывать воспалительные реакции в организме, что, в свою очередь, может привести к увеличению количества нейтрофилов. Практики, такие как медитация, йога и дыхательные упражнения, могут помочь снизить уровень стресса и улучшить общее самочувствие.
Кроме того, важно избегать вредных привычек, таких как курение и чрезмерное употребление алкоголя, которые могут негативно влиять на здоровье и способствовать повышению уровня нейтрофилов. Поддержание нормального веса также является важным фактором, так как избыточный вес может быть связан с хроническими воспалительными процессами в организме.
В заключение, профилактика повышения уровня нейтрофилов требует комплексного подхода, включающего здоровый образ жизни, регулярные медицинские осмотры и управление стрессом. Соблюдение этих рекомендаций поможет не только поддерживать нормальный уровень нейтрофилов, но и улучшить общее состояние здоровья.